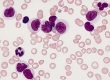
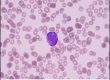
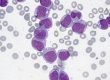
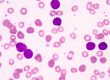

پنل متابولیک جامع (Comprehensive Metabolic Panel) شامل چهارده آزمایش خون است که برای ارزیابی وضعیت سلامت کلی بدن، به خصوص عملکرد کبد و کلیهها، استفاده میشود:
۱. آلبومین (Albumin): یک پروتئین اصلی در خون است که توسط کبد ساخته میشود و نقش مهمی در حفظ فشار اسمزی خون دارد.
۲. آلکالین فسفاتاز (Alkaline Phosphatase): آنزیمی که در بسیاری از بافتها یافت میشود، اما بیشتر در کبد، استخوانها و کیسه صفرا میباشد.
۳. آلانین آمینوترانسفراز (ALT): آنزیمی که عمدتاً در کبد یافت میشود و بالا رفتن سطح آن میتواند نشاندهنده آسیب کبدی باشد.
۴. آسپارتات آمینوترانسفراز (AST): آنزیم موجود در کبد و سایر بافتها. سطح بالای آن میتواند نشاندهنده آسیب کبدی باشد.
۵. کلسیم (Calcium): ماده معدنی مهم برای استخوانها و عملکرد عضلانی.
۶. دی اکسید کربن (Carbon Dioxide): بخشی از تست گازهای خون، که تعادل اسید-باز بدن را نشان میدهد.
۷. کلرید (Chloride): یک الکترولیت مهم که به حفظ تعادل آب و الکترولیتها کمک میکند.
۸. کراتینین (Creatinine): ضایعات متابولیکی که توسط کلیهها دفع میشود و نشاندهنده عملکرد کلیه است.
۹. گلوکز (Glucose): سطح قند خون که برای تشخیص دیابت و سایر شرایط مرتبط با متابولیسم گلوکز مهم است.
۱۰. پتاسیم (Potassium): الکترولیت مهم برای عملکرد قلب و عضلات.
۱۱. سدیم (Sodium): یکی دیگر از الکترولیتهای اصلی، مهم برای تعادل آب و الکترولیتها.
۱۲. بیلیروبین کل (Total Bilirubin): محصول تجزیه هموگلوبین؛ سطوح بالای آن میتواند نشاندهنده مشکلات کبدی یا خونی باشد.
۱۳. پروتئین کل (Total Protein): اندازهگیری کل پروتئینهای خون که شامل آلبومین و گلوبولین میشود.
۱۴. اوره نیتروژن (BUN): سطح اوره در خون که نشاندهنده عملکرد کلیه است.
این آزمایشها به پزشک کمک میکنند تا وضعیت سلامتی کلی بیمار را ارزیابی کند و میتواند در تشخیص بیماریهای مختلف مفید باشد.